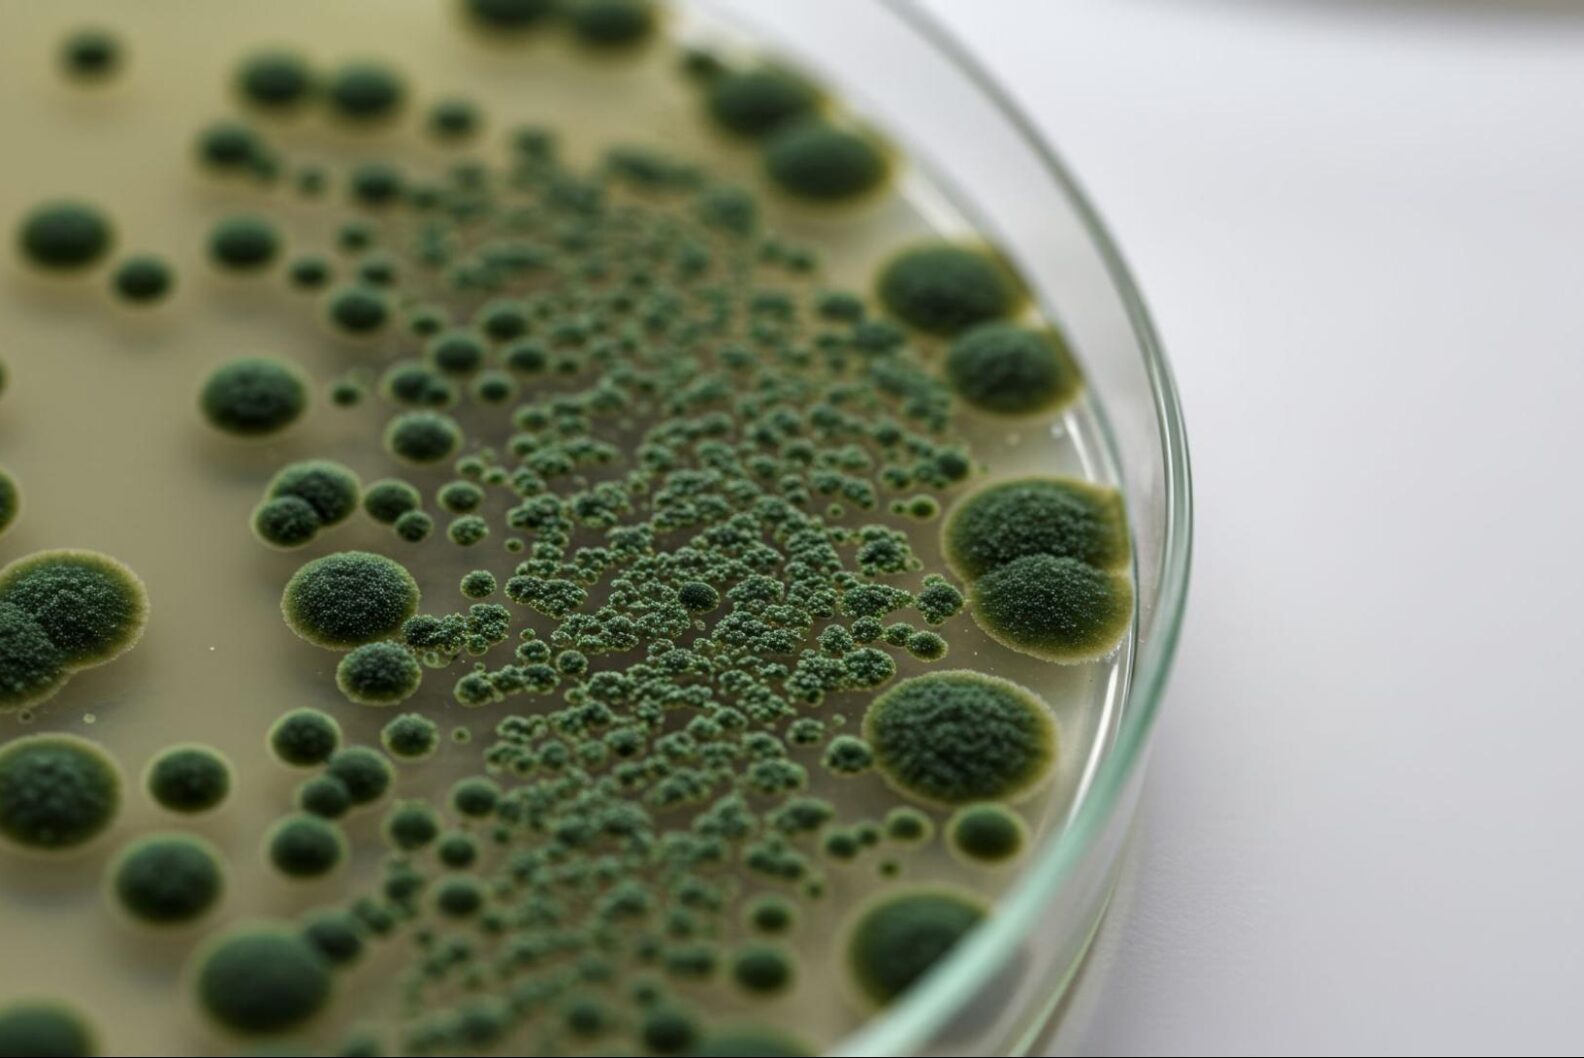

私たちハーツリッチは、これまでカビ原因調査10,000件以上、カビ除去6,015件以上の現場に携わってきました。
その経験の中で断言できることがあります。
原因を誤って判断したまま対策を行うと、カビは高い確率で再発するということです。
実際に、ある清掃会社が空気の滞留が原因と判断した現場を弊社で再調査したところ、
本当の原因は漏水だったというケースもありました。
このように、カビ問題を解決するためには、建築学と生物学の両方に精通した調査員が、信頼性の高い調査方法で原因を特定することが極めて重要です。
しかし実際には、これができる業者は多くありません。
業者選びを間違えた結果、原因を誤診する、カビが再発する、不必要な費用や時間がかかるといったケースが業界では少なくないのが実情です。
そこでこの記事では、これまでの私たちの調査経験をもとに、これが欠けると確実にリスクが高まると言い切れるカビ原因調査の会社選びの5つのポイントを解説します。
チェックポイント | 選ぶべき会社 | 避けるべき会社 |
ポイント(1) 建築と生物学の両方の知識を持っている会社を選ぶ | ・1級建築施工管理技士または建築士の資格を持っている ・大学や研究機関と共同研究を行っている ・AI・データを活用した分析を行っている(あるとベター) | ・左記の資格や経験がない |
ポイント(2) 国家基準に準拠した「浮遊菌調査」を行っている会社を選ぶ | 浮遊菌調査を行っている | 落下菌検査など簡易的な検査しか行っていない |
ポイント(3) 裁判資料にも通用する「客観性・専門性の高い報告書」を作成できる会社を選ぶ | 報告書において ・浮遊菌検査などの信頼性の高い測定データを提示している ・建物構造・環境条件を踏まえた専門的な原因考察がある ・再発防止の具体的な対策提案まで記載されている ・裁判資料や社内稟議でも使える | 報告書において ・測定データがない、あるいは信頼性が低い ・簡易レポートのみで情報が不足している ・専門的な分析がない ・証拠資料として弱い |
ポイント(4) トラブルを収束させる「中立的な紛争解決力」を備えている会社を選ぶ | ・専門的なデータを図解・数値などを用いて誰にでもわかりやすく説明できる ・建物の現場に入るための手続きや調整業務(入館申請・作業申請など)に慣れている | ・納得できる説明ができない ・わかりやすく説明できない ・建物の現場に入るための手続きや調整業務に慣れていない |
ポイント(5) 再発防止まで完遂できる会社を選ぶ | ・再発防止まで一貫して対応している ・家具・衣類・書籍など「モノ」へのカビ対策にも対応できる専門施設(滅菌庫など)を持っている ・カビの種類や環境に合わせて専用液剤を調合できるメーカー機能がある(あればベター) | ・調査だけ、または除菌作業だけなど対応が分断されている ・現場に関係なく同じ方法・同じ薬剤を使用する |
上記のどれか一つでも欠けると失敗リスクは大きく高まります。
カビ原因調査を依頼する際は、必ず5つすべてを満たしているかどうかを確認してください。
目次
ポイント(1)建築と生物学の両方の知識を持っている会社を選ぶ
まず第一に、建築と生物学の両方を理解している会社を選ぶことが必須です。
理由はシンプルで、カビの発生は、建物の構造や環境と、カビという微生物の性質が組み合わさって起こるからです。
例えば、断熱不足による結露、配管からの漏水、換気不足による湿度上昇、建材の含水率の高さなど、建物側の条件によってカビが生えやすい環境がつくられます。一方で、カビは微生物であり、種類ごとに増殖しやすい温度や湿度、付着しやすい素材などの特性が異なります。建物の状態とカビの生物学的特性の両方が重なり、カビは発生・拡散します。
そのため、例えば、建築の知識が不足している場合、本来は建築物の構造的な問題(漏水や断熱不良など)が原因であるにもかかわらず、別の問題(空気の流れ、清掃不足など)と誤診してしまうケースがあります。
実際に、ある清掃会社で「空気の滞留がカビの原因である」と判断した現場をハーツリッチで再調査したところ、実際の原因は漏水だったという誤診事例もあります。
このような誤診を防ぐためにも、以下を満たす会社を選ぶことが重要です。
選ぶべき会社 | 理由 |
1級建築施工管理技士または建築士の資格を持っている | 建築学の視点から原因を診断できる |
大学や研究機関と共同研究を行っている | 生物学の視点からカビの発生要因を分析できる |
AI・データを活用した分析を行っている(あるとベター) | カビ発生の傾向や環境条件をデータから分析できるため、より精度の高い原因特定が可能 |
カビ原因調査では建築と生物学の両方の知見が必要です。これがない会社は原因を誤診し、カビを再発させるリスクがあるので避けてください。
ポイント(2)国家基準に準拠した「浮遊菌調査」を行っている会社を選ぶ
次にチェックしてほしいのが、「浮遊菌調査」を行っている会社を選ぶことです。
カビ問題は建物の問題だけではなく、空気中の菌汚染の問題でもあり、空間中にどれだけカビ菌が存在しているのかを調査できるのが「浮遊菌調査」だからです。
浮遊菌調査は、専用機器で床から1メートルの高さの空気を吸引し、空気中の菌量を測定する調査方法で、空間の汚染レベル、カビの拡散状況をかなり正確に把握できます。文部科学省、日本建築学会、ISO基準でも採用されている、非常に信頼性の高い手法です。
逆に、精度の低い簡易的な検査も存在するため注意が必要です。例えば、安価な会社が行う落下菌検査は、ある地点に培地を置いて菌が落ちてくるのを待つ、簡易的な検査です。
この方法では、空気中の菌量を正確に測定できない、汚染状況を正しく評価できないリスクがあります。結果、空気中の菌汚染が見逃され、カビが再発するといったトラブルリスクがあります。
また、落下菌検査はエビデンスとしての力が弱く、法的資料や厳格な稟議資料としては不十分な場合があるので避けるのが賢明です。
選ぶべき会社 | 避けるべき会社 |
浮遊菌調査を行っている | 落下菌検査など簡易的な検査しか行っていない |
空気中の菌量を数値で把握できる「浮遊菌調査」を実施している会社かどうかを必ず確認してください。
ポイント(3)裁判資料にも通用する「客観性・専門性の高い報告書」を作成できる会社を選ぶ
次に確認すべきは、裁判資料や社内稟議にも通用するレベルの「客観性・専門性の高い報告書」を作成できる会社かどうかです。
カビ問題は、新築物件の施工不良、賃貸物件の管理責任、建物設備の不具合など、責任問題に発展するケースが少なくありません。そのため、調査結果は単なる作業報告ではなく、第三者が見て納得できる客観的な資料として十分な情報が記されている必要があります。
信頼できる会社は、次のような要素を含んだ専門的な調査報告書を作成します。
・調査データ(浮遊菌検査などの測定結果)
・建物構造や環境条件の分析
・原因についての専門考察
・再発防止に向けた具体的な提案
このような報告書があれば、カビ発生の原因を誰もが納得できるよう説明できる、意思決定や稟議が進めやすくなる、裁判資料として活用できるといったメリットがあります。
例えば、私たちハーツリッチは、カビ調査で得られた精密な数値データを基に、各エリアごとの汚染度「清潔区域」「準清潔区域」「汚染区域」などに明確に分類して数値データを記載し、原因、再発防止を詳細にまとめた報告書を作成しています。
▼弊社で作成している報告書の例

一方、簡易的なレポート、作業内容のみを記載した報告書では、原因の説明や責任整理の資料としては不十分です。
カビ原因調査を依頼する際は、客観的なデータと専門的な考察を含んだ報告書を作成できる会社かどうかを必ず確認してください。
確認方法としては、
・会社に問い合わせて報告書のサンプルをもらう
・対面での相談時に報告書の記載内容について直接確認する
などしてみてください。
選ぶべき会社 | 避けるべき会社 |
報告書において ・浮遊菌検査などの信頼性の高い測定データを提示している ・建物構造・環境条件を踏まえた専門的な原因考察がある ・再発防止の具体的な対策提案まで記載されている ・裁判資料や社内稟議でも使える | 報告書において ・測定データがない、あるいは信頼性が低い ・簡易レポートのみで情報が不足している ・専門的な分析がない ・証拠資料として弱い |
ポイント(4)トラブルを収束させる「中立的な紛争解決力」を備えている会社を選ぶ
特に施主や施工会社が揉めている場合に確認すべきは、中立的にトラブルを収束させる力を持っている会社かどうかです。
例えば、新築物件では「施工不良なのか」、賃貸物件では「管理側の問題なのか、居住者の使用環境なのか」、といった責任の所在を巡るトラブルに発展することが少なくありません。
このような状況では、単に調査を行うだけではなく、建築と環境の両面から原因を整理し、第三者の専門家として客観的に状況を説明できる能力が必須です。
信頼できる会社は、調査結果をもとに、建物構造(断熱・結露・漏水など)、室内環境(湿度・換気状況など)を総合的に分析し、図解やデータを用いて原因を分かりやすく説明できます。
もしこのような専門的な説明ができない場合、責任の押し付け合いが続き、問題が長期化するリスクがあります。
また、建物の現場に入るための手続きや調整業務(入館申請・作業申請など)に慣れていることも重要です。
特に、ホテル・商業施設・オフィスビルなどでは施設管理のルールが厳しく、事前申請や作業計画書の提出などの手続きが必要になる場合があります。
こうした現場管理事務に慣れている会社であれば、施設管理側との調整もスムーズに進み、調査や作業を円滑に実行できます。
選ぶべき会社 | 避けるべき会社 |
・専門的なデータを図解・数値などを用いて誰にでもわかりやすく説明できる ・建物の現場に入るための手続きや調整業務(入館申請・作業申請など)に慣れている | ・納得できる説明ができない ・わかりやすく説明できない ・建物の現場に入るための手続きや調整業務に慣れていない |
ポイント(5)再発防止まで完遂できる会社を選ぶ
最後に確認したいのは、調査だけで終わらず、再発防止まで対応できる一貫体制が整っている会社かどうかです。
カビ問題では、原因を特定することも重要ですが、その後に適切な提案・対策を実行できるかどうかが再発防止の鍵になります。
具体的には、建物だけでなく「物品」へのカビ対策まで対応できる体制が整っている会社であれば、根本解決できる可能性が高いです。
カビは壁や天井などの建物だけでなく、室内にある家具・衣類・書籍・美術品などの物品にも発生・付着します。
建物の除菌だけを行っても、これらの物品にカビ菌が残っていると、空気中に胞子が再び拡散し、カビが再発する可能性があります。
根本解決できる会社は、家具、衣類、書籍、美術品などに付着したカビに対して、ガス滅菌などの専門技術や専用設備を用いて除菌できる体制を持っています。
これに加えて、専用薬剤を開発できるメーカー機能を持っている会社であれば、より理想的です。
カビは種類や発生環境によって性質が異なるため、すべての現場で同じ薬剤を使用すると、十分な効果が得られない場合があります。
カビの種類、現場の温度・湿度、発生している場所(壁・木材・水回りなど)といった条件を踏まえ、成分を0.1%刻みで調整した一点物の液剤を開発する体制を持っている会社であれば、より精度の高い対策が期待できます。
選ぶべき会社 | 避けるべき会社 |
・再発防止まで一貫して対応している ・家具・衣類・書籍など「物品」へのカビ対策にも対応できる専門施設(滅菌庫など)を持っている ・カビの種類や環境に合わせて専用液剤を調合できるメーカー機能がある(あればベター) | ・調査だけ、または除菌作業だけなど対応が分断されている ・現場に関係なく同じ方法・同じ薬剤を使用する |
カビ原因調査を依頼する際は、調査だけで終わる会社ではなく、必ず再発防止まで一貫して対応できる体制があるかを確認してください。
まとめ
本記事で挙げた5つの基準は、後から後悔しないために、失敗リスクの高い調査会社をあらかじめ見極めるための必須チェック項目です。
- ポイント(1)建築と生物学の両方の知識を持っている会社を選ぶ
- ポイント(2)国家基準に準拠した「浮遊菌調査」を行っている会社を選ぶ
- ポイント(3)裁判資料にも通用する「客観性・専門性の高い報告書」を作成できる会社を選ぶ
- ポイント(4)トラブルを収束させる「中立的な紛争解決力」を備えている会社を選ぶ
- ポイント(5)再発防止まで完遂できる会社を選ぶ
繰り返しになりますが、カビ原因調査を正確に行える知識と技術を持った会社は決して多くありません。
そのため、依頼先をしっかり確認して選ぶことが非常に重要です。
この記事を参考に、信頼できる会社に依頼し、カビ問題を根本から解決できることを願っています。
最後に、私たちハーツリッチは、カビ原因調査10,000件以上、カビ除去6,015件以上の現場に携わってきました。
ハーツリッチのサービス内容や強みについては別記事で詳しく紹介していますので、よろしければあわせてご覧ください。

